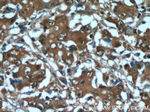
GGCT Antibody in Immunohistochemistry (Paraffin) (IHC (P))

Search
Proteintech
GGCT Polyclonal Antibody
{{$productOrderCtrl.translations['antibody.pdp.commerceCard.promotion.promotions']}}
{{$productOrderCtrl.translations['antibody.pdp.commerceCard.promotion.viewpromo']}}
{{$productOrderCtrl.translations['antibody.pdp.commerceCard.promotion.promocode']}}: {{promo.promoCode}} {{promo.promoTitle}} {{promo.promoDescription}}. {{$productOrderCtrl.translations['antibody.pdp.commerceCard.promotion.learnmore']}}
产品信息
16257-1-AP
种属反应
已发表种属
宿主/亚型
分类
类型
抗原
偶联物
形式
浓度
规格
纯化类型
保存液
内含物
保存条件
运输条件
产品详细信息
Immunogen sequence: MANSGCKDV TGPDEESFLY FAYGSNLLTE RIHLRNPSAA FFCVARLQDF KLDFGNSQGK TSQTWHGGIA TIFQSPGDEV WGVVWKMNKS NLNSLDEQEG VKSGMYVVIE VKVATQEGKE ITCRSYLMTN YESAPPSPQY KKIICMGAKE NGLPLEYQEK LKAIEPNDYT GKVSEEIEDI IKKGETQTL (1-188 aa encoded by BC019243 )
靶标信息
GGCT (EC 2.3.2.4) catalyzes the formation of 5-oxoproline (pyroglutamic acid) from gamma-glutamyl dipeptides and may play a significant role in glutathione homeostasis.
仅用于科研。不用于诊断过程。未经明确授权不得转售。
生物信息学
蛋白别名: Cytochrome c-releasing factor 21; gamma -glutamyl cyclotransferase; gamma-glutamyl cyclotransferase-like 1; Gamma-glutamylcyclotransferase; unnamed protein product
基因别名: A030007L17Rik; AA673177; C7orf24; CRF21; GCTG; GGC; GGCT; Ggctl1; RGD1304876; RGD1562590
UniProt ID: (Human) O75223, (Mouse) Q9D7X8
Entrez Gene ID: (Human) 79017, (Mouse) 110175, (Rat) 362368